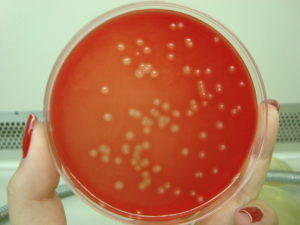
Стрептококк агалактия
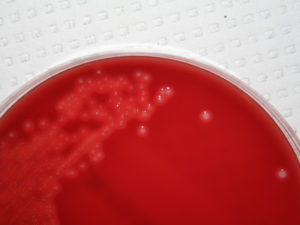
Стрептококк агалактия

Streptococcus agalactiae в мазке из влагалища, уретры и цервикального канала — что делать, если выявлен
В статье про кокковую флору мы рассказали о различных микроорганизмах, которые тем или иным образом могут навредить женским репродуктивным органам. Большинство живущих во влагалище кокков — условно-патогенные, обычные представители флоры.
Но иногда их наличие крайне нежелательно. Так, в конце беременности большую опасность представляют стрептококки группы B (Strept.
Agalactiae) или стрептококк агалактия — это грамположительный микроорганизм — возбудитель смертельно опасных заболеваний.
Бактерии живут во влагалище и кишечнике у каждой 3-4 женщины. И это не венерическая болезнь. Однако данные микроорганизмы, как и любые другие, могут передаваться от одного полового партнера к другому. В большинстве случаев бета-гемолитический стрептококк не вызывает болезни. Но у некоторых людей могут провоцировать тяжелые инфекции или Б-стрептококковую болезнь (БСБ).
К содержанию
Чем и для кого опасна б-стрептококковая болезнь, пути передачи инфекции
Streptococcus agalactiae провоцирует:
- инфекцию мочевыделительной системы;
- послеродовые осложнения;
- пневмонию;
- неонатальный сепсис;
- эндокардит;
- менингит;
- артрит.
В группу риска входят новорожденные дети, особенно недоношенные, а также взрослые люди с хроническими заболеваниями и низким иммунитетом, пожилые.
В США проводили подсчет новорожденных, у которых за определенный промежуток времени был диагностирован стрептококковый менингит. Это около 8000 детей. И 800 из них умирает. А у каждого пятого из оставшихся в живых бывают осложнения: потеря зрения, слуха, умственная отсталость и паралич.
Как заражаются новорожденные? Обычно это происходит во время естественных родов, кесарева сечения или преждевременном разрыве плодных оболочек — даже если это так называемый верхний боковой надрыв, когда воды только немного подтекают. Инфекция таким образом попадает в воды, которые заглатывает малыш.
Есть мнение, что инфекция способна проникнуть в организм ребенка и при сохраненных плодных оболочках вне родов, вызвав внутриутробную гибель плода или выкидыш. Однако научных подтверждений тому нет.
К содержанию
Как диагностируется носительство стрептококка агалактия и симптомы заболевания
Когда женщина просто носитель бактерии со здоровой, палочковой микрофлорой влагалища и не высокими лейкоцитами, никаких признаков инфекции у нее нет. Если же количество стрептококка group b растет, то появляются следующие симптомы:
- зуд и жжение в области половых губ и влагалища;
- необычные выделения, чаще желтые.
Если женщина в период появления данной симптоматики сдает мазок на флору, то в нем определяется множество кокков и увеличенное число лейкоцитов. Тогда врач сразу назначает лечение либо направляет анализ женщины на бакпосев для диагностики конкретного возбудителя заболевания и определения его чувствительности к тому или иному антибактериальному средству.
В норме streptococcus agalactiae либо отсутствует в микрофлоре влагалища и цервикального канала, либо находится там в небольшом количестве — 10 в 3 или 10 в 4 степени. Если же его наличие подсчитано как 10 в 5, 6, 7 степени и более — требуется лечение.
К содержанию
Когда нужно лечиться и какими препаратами при выявлении стрептококка группы В
Мы рассмотрим 4 ситуации.
1. Женщина, планирующая беременность.
Если в ходе обследования в мазке выявлен этот микроорганизм, лечение проводится только при вагинальном дискомфорте. Если же все хорошо, никаких препятствий для зачатия и вынашивания ребенка нет.
2. Женщина, не планирующая в ближайшем будущем ребенка, но имеющая симптомы.
Если в посеве мочи все чисто, то достаточно местного лечения (вагинальных свечей или таблеток).
3. Беременная, у которой в плановом порядке был выявлен стрептококк агалактия методом ПЦР в мазке или в бакпосеве.
Если болезнетворная бактерия была обнаружена при плановом обследовании задолго до родов, а признаков воспалительного процесса нет, назначается сдать бакпосев на сроке 34-35 недель.

Лечение проводится непосредственно перед родами или даже в родах или после отхождения околоплодных вод. Но не менее, чем за 4 часа до появления ребенка на свет.
Беременной вводят внутримышечно или внутривенно антибиотики пенициллиновой группы, макролиды или цефалоспорины.
Колоть антибиотики за несколько недель до родов не имеет особого смысла, так как стрептококк вновь заселит влагалище вскоре после окончания терапии.
4. Кормящая мать. При наличии признаков недуга во время лактации, рекомендуют лечение без антибиотиков — препаратами местного действия. Достаточно свечей «Гексикон» (хлоргексидин) по одному и два суппозитория в день в течение одной недели. Затем любой вагинальный препарат, содержащий лактобактерии.
Чтобы не быть голословными, мы изучили различные отзывы женщин об избавлении от потенциально опасных стрептококков gr.b. И вот такие методы лечения мы нашли.
| Вариант антибактериального местного лечения | Метромикон-нео по 1 суппозиторию утром и на ночь в течение 7 дней подряд. |
| Комплексная схема для 1-2 триместра беременности | Амоксиклав по 1 таб. 375 мг каждые 8 ч + свечи «Гексикон» вагинально 7 дней по 1 на ночь. |
| Комбинированное лечение | Азитромицин 1 г однократно;Ветадин по 1 св. №10;Трихопол по 1 таб. 3 р/день №7;Дифлюкан однократно. |
| Санация влагалища антисептиком | Свечи Флуамизин — 1 вагинальная таб./сут (6 дней). |
Также для лечения используются следующие антибиотики:
- Бензилпенициллин (Benzylpenicillin);
- Ванкомицин (Vancomycin);
- Доксициклин (Doxycycline);
- Левофлоксацин (Levofloxacin);
- Линезолид (Linezolid);
- Фосфомицин (Fosfomycin);
- Цефтриаксон (Ceftriaxone).
Системный (внутрь) прием антибиотика обязательно нужен при обнаружении бактерии в моче у беременной.
К содержанию
Стрептококк агалактия в мазке или моче у мужчин и женщин, лечение и профилактика
Стрептококки агалактия (streptococcus agalactiae) – микроорганизмы семейства Стрептококковые. Они являются условно-патогенной разновидностью бактерий. Микроорганизмы в небольшом объеме могут существовать в теле человека, не угрожая при этом здоровью. Бактерии обитают в органах мочевыделительной и половой систем. Стрептококки агалактия имеют форму шара или овала.
Проникая в организм, размещаются парно, в виде цепочки. При нарушении нормального баланса микрофлоры концентрация стрептококков агалактия начинает стремительно увеличиваться, провоцируя острые воспалительные процессы.
Разновидности
Существует более 40 видов стрептококков.
Их объединяют в 4 основные группы:
Стрептококк агалактия принадлежит к группе бета-гемолитических стрептококков. Впервые он был обнаружен у коров, больных маститом.
Способы заражения
Микроорганизм обитает преимущественно в урогенитальном тракте, прямой кишке и верхнем отделе глотки. Инфицирование происходит чаще всего половым путем. Другими способами заражения являются:
У мужчин заражение streptococcus agalactiae происходит при незащищенном сексе или снижении защитных сил организма.
У женщин активация патогенных микроорганизмов наблюдается при:
Причиной роста и размножения стрептококков агалактия у представителей обоих полов может быть также сахарный диабет.
Заражение новорожденного
Инфицирование происходит чаще всего во время прохождения по родовым путям, реже – при контакте с матерью или персоналом роддома.
Предрасполагающими к развитию стрептококковой инфекции у грудного ребенка являются определенные факторы:
Иногда заражение происходит внутриутробно.
Инфицирование возможно при выполнении диагностических и лечебных манипуляций:
Заражение стрептококком агалактия в подобных случаях – результат несоблюдения правил асептики.
Признаки
При увеличении количества условно-патогенных бактерий в женском организме, развивается определенная симптоматика.
Основными проявлениями воспалительного процесса становятся:
Чрезмерная концентрация streptococcus agalactiae в мазке у женщин (более чем 10*5 КОЕ/мл) обычно указывает на цистит или вульвовагинит.
https://youtube.com/watch?v=z78XrLMkz9E
Патологический процесс, спровоцированный стрептококками агалактия, у мужчин вызывает чаще всего воспаление мочеиспускательного канала и мочевого пузыря.
Основные проявления:
У мужчин может наблюдаться также небольшое воспаление и выделения с гнойным содержимым из полового члена.
Стрептококк агалактия при беременности
В период вынашивания ребенка происходит перестройка гормонального фона женщины. Увеличивается концентрация прогестерона, снижается иммунитет. В результате возможно обострение различных инфекций органов мочеполовой системы.
В группе повышенного риска по развитию патологического состояния находятся:
Частым осложнением воспалительного процесса, спровоцированного условно-патогенными бактериями, является послеродовой эндометрит.
Обследование беременных с повышенным риском развития инфекции или уже имеющих ее включает:
Диагностика выполняется на последнем месяце беременности. К этому сроку концентрация бактерий достигает наибольшего количества.
Обследования
Диагностирование воспалительного процесса у мужчин и женщин объединяет лабораторные и инструментальные способы.
Главные исследования:
Комплексное обследование помогает специалисту определить диагноз и подобрать адекватное лечение.
Терапия
Лечение стрептококка агалактия выполняется антибиотиками. Курс терапии продолжается не менее 5 дней.
Эффективными препаратами являются:
При аллергии на антибиотики назначаются макролиды (Эритромицин, Азитромицин, Джозамицин).
Женщинам может быть рекомендован Гексикон. Это вагинальные свечи, оказывающие антисептическое и дезинфицирующее действие.
В некоторых случаях терапия дополняется стрептококковыми бактериофагами.
Для нормализации работы ЖКТ назначаются пробиотики (Линекс, Бифидумабактерин, Ацилакт, Аципол).
Сорбенты (Атоксил, Полисорб, Альбумин, Смекта) способствуют качественному выведению токсинов.
Применение иммуностимуляторов (Лизобакт, Имунорикс, Имудон) позволяет улучшить состояние иммунитета и усилить действие антибиотиков.
При возникновении аллергических реакций назначаются антигистаминные препараты (Цетрин, Кларитин).
Лечение при беременности
Если существует опасность инфицирования ребенка при родах, то терапия антибактериальными препаратами выполняется непосредственно в процессе родоразрешения, а также после разрыва околоплодного пузыря и отхождения амниотической жидкости. Более раннее лечение не будет достаточно эффективным, патогенные микроорганизмы продолжат размножение. Для санации влагалища могут быть назначены вагинальные таблетки и свечи (Флуомизин, Тержинан, Гексикон).
Лечение стрептококка агалактии проводится под контролем врача. Все рекомендации должны выполняться. Санация влагалища или терапия антибиотиками помогают уменьшить риск заражения ребенка.
Возможные осложнения
Размножение условно-патогенных бактерий приводит к выделению токсических веществ, которые с током крови разносятся во все системы и органы.
Они воздействуют на защитные способности организма, вызывая аутоиммунные заболевания:
У беременных, имеющих высокий титр концентрации стрептококков агалактия в мазке или моче, при отсутствии своевременной терапии могут возникнуть серьезные осложнения.
Чаще всего развивается:
У грудного ребенка заражение стрептококком агалактия может вызвать не менее тяжелые последствия.
Возможно:
Летальный исход отмечается более чем в половине случаев заражения новорожденных.
Народные средства
Естественный иммуностимулятор – аскорбиновая кислота (витамин С). Полезного вещества много в шиповнике, клюкве, лимоне, облепихе, смородине, калине.
Популярными рецептами для лечения стрептококка агалактия являются:
Важно включить в ежедневный рацион лук и чеснок. Эти растения являются природными антибиотиками и антиоксидантами, источниками комплекса витаминов. Свежие абрикосы, принимаемые внутрь при стрептококковой инфекции, также эффективно уничтожают условно-патогенные бактерии.
Профилактика
Выполнение профилактических мероприятий помогает снизить вероятность заражения стрептококком агалактия.
Основными рекомендациями являются:
Активизация стрептококка агалактии – серьезная опасность для здоровья. Микроорганизмы, размножаясь, провоцируют распад эритроцитов. Своевременная диагностика и терапия помогают избежать развития различных осложнений.
Загрузка…
Характеристика Streptococcus agalactiae, морфология, патология / биология
Streptococcus agalactiae, Также известный как бета-гемолитический стрептококк группы B, он является грамположительной бактерией, основной причиной заболеваний в неонатальном и перинатальном периодах. Обычно он обнаруживается как нормальная микробиота нижних отделов желудочно-кишечного тракта, но оттуда он может колонизировать другие участки, находящиеся в женских половых путях и в глотке..
Процент беременных женщин-носителей Streptococcus agalactiae это 10% -40%, а скорость передачи новорожденным составляет 50%. Из колонизированных новорожденных примерно заболеют из-за этого 1-2% бактерий.
У новорожденных, Streptococcus agalactiae может вызывать сепсис, менингит и респираторные инфекции, а у матери может вызывать послеродовые инфекции и инфекции ран, среди прочего.
Этот микроорганизм также ведет себя как патоген животных. Он был основной причиной бычьего мастита, прерывая производство промышленного молока, поэтому его название происходит от agalactiae, что означает отсутствие молока.
индекс
- 1 Характеристики
- 2 Таксономия
- 3 Морфология
- 4 Передача
- 5 Патогенез
- 6 Патология и клинические проявления
- 6.1 У новорожденного
- 6.2 В колонизированной матери
- 6.3. Дети старшего возраста, небеременные женщины и мужчины
- 7 Профилактика
- 8 Диагноз
- 9 Лечение
- 10 ссылок
черты
S. agalactiae Он характеризуется факультативным анаэробным действием, хорошо растет в средах, обогащенных кровью, при 36 или 37 ° С в течение 24 часов инкубации. Их рост благоприятен, если они инкубируются в атмосфере с 5-7% углекислого газа.

В кровяном агаре они вызывают ореол полного гемолиза вокруг колонии (бета-гемолиз) благодаря выработке гемолизинов, хотя полученный гемолиз не так выражен, как у других стрептококков.
В Новой Гранаде агар обладает способностью продуцировать патогномоничный оранжевый пигмент вида.
С другой стороны, S. agalactiae это каталаза и отрицательная оксидаза.
таксономия
Streptococcus agalactiae относится к домену бактерии, Phylum Firmicutes, класс Bacilli, отряд Lactobacillales, семейство Streptococaceae, род Streptococcus, вид agalactiae.
Принадлежит к группе B согласно классификации Lancefield.
морфология
Streptococcus agalactiae грамположительные кокки, которые расположены в виде коротких цепочек и диплококков.
На кровяном агаре могут наблюдаться колонии немного большего размера и с менее выраженным бета-гемолизом, чем у стрептококков группы А..
Этот микроорганизм имеет полисахаридную капсулу девяти антигенных типов (Ia, Ib, II, — VIII). Все обладают сиаловой кислотой.
Антиген группы В присутствует в клеточной стенке.
передача
Передача бактерий от матери ребенку происходит в основном вертикально. Ребенок может быть заражен либо в утробе матери, когда бактерии достигают околоплодных вод или при прохождении ребенка через родовой канал.
Риск передачи от матери к ребенку выше, когда существуют предрасполагающие факторы. Среди них:
- Преждевременные роды,
- Разрыв амниотической мембраны за 18 или более часов до родов,
- Акушерские манипуляции,
- Внутри родовая лихорадка,
- Длительный труд,
- Послеродовая бактериемия,
- Материнский амнионит,
- Плотная вагинальная колонизация S. agalactiae,
- Бактериурия из-за этого микроорганизма
- Предшественники предыдущих родов с ранним заражением.
Хотя также было видно, что он может быть колонизирован внутрибольничным воздействием после рождения.
патогенез
Механизм вирулентности, создаваемый этой бактерией, направлен на ослабление защитных систем пациента для проникновения в ткани. Среди факторов вирулентности капсула, в первую очередь богатая сиаловой кислотой и бета-гемолизином.
Однако также было идентифицировано множество белков поверхностного и внеклеточного матрикса, которые способны связываться с фибронектином..
В дополнение к этому сиаловая кислота связывает сывороточный фактор H, который ускоряет выведение комплемента C3b, прежде чем он сможет опсонизировать бактерию..
Конечно, это делает линию защиты врожденного иммунитета через фагоцитоз, опосредованную альтернативным путем комплемента, неэффективной.
Следовательно, единственный возможный вариант защиты заключается в активации комплемента классическим путем, но это имеет недостаток, который требует присутствия антител определенного типа..
Но чтобы у новорожденного было это антитело, мать должна обеспечить его через плаценту. В противном случае новорожденный не защищен от этого микроорганизма..
В дополнение к этому, S. agalactiae продуцирует пептидазу, которая отключает C5a, что приводит к очень плохому хемотаксису полиморфно-ядерных лейкоцитов (PMN).
Это объясняет, почему тяжелые неонатальные инфекции присутствуют с небольшим присутствием PMN (нейтропения).
У новорожденного
Как правило, признаки заражения новорожденного обнаруживаются при рождении (от 12 до 20 часов труда до первых 5 дней) (раннее начало).
Начните наблюдать неспецифические признаки, такие как раздражительность, отсутствие аппетита, проблемы с дыханием, желтуха, гипотония, лихорадка или иногда может быть гипотермией.
Эти признаки развиваются, и последующим диагнозом могут быть сепсис, менингит, пневмония или септический шок, при этом уровень смертности у детей, родившихся в возрасте от 2 до 8%, значительно увеличивается у недоношенных детей..

В других случаях позднее начало может наблюдаться с 7-го дня рождения до 1-3 месяцев спустя, с менингитом и очаговыми инфекциями в костях и суставах, с уровнем смертности от 10 до 15%.
Случаи позднего менингита могут оставлять постоянные неврологические последствия примерно в 50% случаев..
В колонизированной матери
С точки зрения матери, он может представлять хориоамнионит и бактериемию в перипарту..
Может также развиться послеродовой эндометрит, посткесаревая бактериемия и бессимптомная бактериурия во время и после родов.
Другими поражениями этой бактерии у взрослых могут быть менингит, пневмония, эндокардит, фашит, внутрибрюшные абсцессы и кожные инфекции..
Тем не менее, заболевание у взрослых, даже в тяжелых случаях, обычно не приводит к смертельному исходу, а у новорожденных с уровнем смертности до 10% — 15%.
Дети старшего возраста, небеременные женщины и мужчины
Этот микроорганизм также может поражать детей старшего возраста, небеременных женщин и даже мужчин..
Это обычно ослабленные пациенты, где S. agalactiae может вызывать пневмонию с эмпиемой и плевральным выпотом, септическим артритом, остеомиелитом, инфекциями мочевыводящих путей, циститом, пиелонефритом и инфекциями мягких тканей от целлюлита до некротического фасциита.
Другими редкими осложнениями могут быть конъюнктивит, кератит и эндофтальмит.
профилактика
Естественным образом плод может быть защищен в перинатальном периоде. Это возможно, если мать имеет антитела IgG против специфического капсульного антигена Streptococcus agalactiae который колонизирован.
Антитела IgG способны проникать через плаценту, и это защищает.
Если вместо этого антитела IgG, присутствующие в матери, против другого капсульного антигена, отличного от типа S. agalactiae который колонизирует в то время, они не защитят новорожденного.
К счастью, существует всего девять серотипов, и наиболее часто встречается тип III.
Однако акушеры обычно предотвращают заболевание новорожденных, назначая матери внутривенно ампициллин с профилактической целью во время родов..
Это должно быть сделано до тех пор, пока мать имеет положительную культуру влагалища для S. agalactiae в третьем триместре беременности (от 35 до 37 недель).
Тем не менее, эта мера предотвратит раннее заболевание у новорожденного в 70% случаев, имея низкую защиту от позднего заболевания, так как это в основном вызвано внешними факторами после рождения.
Если у матери аллергия на пенициллин, можно использовать цефазолин, клиндамицин или ванкомицин.
диагностика
Для диагностики идеальным является выделение микроорганизма из таких проб, как кровь, CSF, мокрота, выделения из влагалища, моча и другие..
Растет на кровяном агаре и на гранадском агаре. В обоих случаях представлены конкретные характеристики; в первой наблюдаются бета-гемолитические колонии, а во второй — оранжево-лососевые колонии.
К сожалению, 5% изолятов не представляют гемолиз или пигмент, поэтому они не будут обнаружены с помощью этих средств.
Выявление капсульных антигенов S. agalactiae в CSF сыворотка, моча и чистые культуры возможны методом латекс-агглютинации с использованием специфической антисыворотки.
Аналогично, тест для определения фактора САМР очень распространен для идентификации вида. Это внеклеточный белок, который действует синергетически с ß-лизином Золотистый стафилококк когда он посеян перпендикулярно S. agalactiae, создавая большую область гемолиза в форме стрелки.
Другими важными диагностическими тестами являются тест на гипурато и аргинин. Оба дают позитив.
лечение
Эффективно лечится пенициллином или ампициллином. Иногда его обычно комбинируют с аминогликозидом, потому что его введение в целом обладает синергетическим эффектом, в дополнение к увеличению спектра действия в случаях инфекций, связанных с другими бактериями..
ссылки
- Участники Википедии. Streptococcus agalactiae. Википедия, Свободная энциклопедия. 24 августа 2018 года, 15:43 UTC. Доступно по адресу: en.wikipedia.org/ По состоянию на 4 сентября 2018 г..
- Райан К.Дж., Рэй С. Sherris. микробиология Medical, 6th edition McGraw-Hill, Нью-Йорк, США; 2010. с. 688-693
- Montes M, García J. Genus Streptococcus: практический обзор для лаборатории микробиологии Enferm Infecc Microbiol Clin 2007; 25 Suppl 3: 14-20
- Koneman, E, Allen, S, Janda, W, Schreckenberger, P, Winn, W. (2004). Микробиологический диагноз. (5-е изд.). Аргентина, редакция Panamericana S.A..
- Морвен Е, Бейкер С. Streptococcus agalactiae (Группа B Streptococcus), «Принципы и практика инфекционных болезней» Манделла, Дугласа и Беннета (восьмое издание), 2015 г .; 2 (1): 2340-2348
- Аптон А. Беременная пациентка с предшествующей беременностью, осложненной стрептококковой болезнью группы В у ребенка. Синдромы по системе организма: ПРАКТИКА Акушерских и Гинекологических Инфекций. Инфекционные Болезни (Четвертое издание) 2017; 1 (1): 520-522
Стрептококк агалактия в мазке: лечение, причины появления
Стрептококки группы B (Streptococcus agalactiae) входят в нормальную микрофлору человека, поэтому стрептококк агалактия в мазке – это явление довольно частое.
Данные микроорганизмы обнаруживаются во влагалищной флоре, половых путях и пищеварительном тракте.
При этом носители таких бактерий не имеют абсолютно никаких симптомов и чувствуют себя здоровыми.
Однако внутренние очаги инфекции у женщин негативно действуют на некоторых новорожденных, провоцируя возникновение целого ряда тяжелых заболеваний.
Стрептококки агалактия
Streptococcus agalactiae привлекают внимание множества медицинских специалистов, поскольку вызывают инфекционные заболевания мочеполовой системы.
При этом зуд, боли, воспалительные процессы, сопровождающиеся гнойными, кровянистыми выделениями, характеризуют целый ряд инфекций, вызванных различными возбудителями.
Streptococcus agalactiae представляют собой бета-гемолитические стрептококки группы B. Эти сферические или овальные микроорганизмы имеют капсулы и образуют своеобразную цепочку, располагаясь попарно.
В условиях лаборатории такие стрептококки, которые являются возбудителями заболеваний, диагностируются без особых проблем.
Этих возбудителей инфекции зачастую выделяют из влагалища у женщин и уретры мужчин, поэтому передаются они большей частью половым путем.
Клиническими проявлениями болезнетворных стрептококков при патологическом обострении инфекции являются жжение уретры мужчин при мочеиспускании, эякуляции, обилие слизи, тянущие боли в области яичников у женщин при занятии сексом, отечность половых губ.
Кроме того, данные возбудители инфекции могут локализоваться внутри горла человека.
Данный вид стрептококка часто составляет микрофлору влагалища беременных женщин. При этом, хотя у самих беременных отсутствуют какие-либо симптомы, возрастает риск возникновения тонзиллита, фарингита, эндометрита, инфекций мочевыводящих путей, послеродового сепсиса.
Инфицированность беременной женщины с большой долей вероятности отразится на ребенке.
При этом опасность инфекционного заражения ребенка во время родов возрастает.
А активированный стрептококк может спровоцировать развитие пневмонии, менингита, неврологические осложнения, сепсис.
Беременность у женщин, инфицированных данным видом стрептококка, вероятнее всего может закончиться преждевременными родами.
READ О чем говорит псевдомицелий в мазке и что это такое?
Таким образом, если стрептококк агалактия выявляется в мазке беременных женщин, то требуется незамедлительное врачебное вмешательство и проведение эффективной комплексной терапии.
Первопричины и способы появления
До трети всех бактерий внутренней среды организма человека составляют стрептококки.
Наибольшее их количество сосредотачивается внутри кишечника, но также они присутствуют на коже, половых органах, внутри ротовой полости и на слизистой оболочке дыхательных путей.
При ослаблении иммунитета появление стрептококков группы B внутри организма – это явный повод для развития инфекционных заболеваний и воспалительных процессов.
Например, стрептококковый тонзиллит, фарингит, инфекции мочеполовой системы, эндометрит, сепсис возникает на фоне патогенной среды, благоприятной для развития заболевания.
:
Причины попадания стрептококков в организм человека могут быть внутренними и внешними.
При ежедневном приеме пищи через грязные руки на фоне плохих санитарно-гигиенических условий стрептококки чаще всего проникают в ротовую полость и желудочно-кишечный тракт.
Кроме того, инфекция может передаваться воздушно-капельным, бытовым, половым путем, а также от зараженной матери к ребенку через плаценту.
Причины самозаражения кроются в нескольких ключевых факторах: инфекционных заболеваниях внутри полости рта, хирургическом удалении миндалин, самостоятельном выдавливании гнойных фурункулов, стоматологических операционных процедурах, хроническом бронхите.
Если стрептококковая инфекция локализуется в дыхательных путях, то это представляет особую опасность для общего состояния организма.
Такие заболевания, как бронхит, пневмония, отит, менингит, гнойная ангина, скарлатина и абсцесс мягких тканей могут быть легко спровоцированными стрептококком под названием агалактия.
:
При начале инфекции воспалительные процессы заболевания развиваются очень быстро, поражая близлежащие ткани.
READ Повышение количества лейкоцитов в мазке при беременности
Половые органы мужчин стрептококки агалактия инфицируются несколькими способами:
- гематогенным путем из инфицированной носоглотки;
- посредством мочи из пораженных почек;
- при дисбактериозе из кишечника через его стенки;
- половым путем при оральном или анальном сексе.
Если мужчина имеет в качестве полового партнера женщину, которая заражена данным видом стрептококка, то инфекция поражает его мочеиспускательный канал.

А самозаражение женщин происходит бактериями из заднего прохода, которые попадают во влагалище разными способами.
Женщины, ведущие активную половую жизнь, имеют большую вероятность скрытого заражения стрептококками данной группы.
Характерным для инфекции Streptococcus agalactiae у мужчин и женщин есть отсутствие четко выраженных симптомов.
Воспаления влагалища и мочеиспускательного канала женщин происходит достаточно редко. С другой стороны, обычным явлением можно считать цистит, особенно у беременных женщин.
Такие проявления опасны для протекания беременности, родов и здоровья будущего ребенка.
Инфекция у новорожденных детей проявляется на третьи сутки их жизни в виде пневмонии, а на более поздних стадиях заболевания – менингита.
Выявление инфекции и лечение
Диагноз инфекционного заболевания, вызванного стрептококками агалактия, подтверждается анализами мочи, окраской мазка по Граму.
Наиболее популярным является культуральный метод. При этом в третьем триместре беременности диагностический мазок из влагалища для выявления данных микроорганизмов просто необходим.
При положительном диагнозе, который подтверждает наличие инфекции, назначаются терапевтические процедуры, призванные подавить патогенный стрептококк.
При таких случаях назначаются антибиотики пенициллиновой группы, цефалоспорины, макролиды, а лечение проводится в течение десяти дней.
Важнейшее значение имеют также профилактические мероприятия для предупреждения более серьезного заболевания.
Начинать лечение рекомендуется с применения «Нитрофурантоина», поскольку этот препарат отличается достаточно большой универсальностью и действует на множество видов бактерий.
READ Где и как сдается анализ на грибок ногтей?
При обнаружении стрептококков группы B назначается «Ампициллин», который накапливается в моче, секрете и стенках влагалища.
Такая особенность данного препарата повышает вероятность эффективной профилактики заражения стрептококком новорожденного младенца.
Кроме того, для предотвращения инфицирования будущего ребенка беременной женщины следует особое внимание уделять соблюдению правил личной гигиены, поскольку обсеменение влагалища может происходить из прямой кишки.
С другой стороны, определенную опасность заражения несет незащищенный секс. При соблюдении таких правил и применении данных медикаментозных средств удается не допустить заражения младенца стрептококком.
Лечение инфекционных заболеваний, вызванных стрептококком алагактии, производится с использованием антибиотиков.
Больше всего применяются антибиотики пенициллиновой группы и цефалоспорины. При этом приоритет не отдается какому-то отдельному препарату, а используется комплексная терапия инфекции.
Существует опасность самолечения, которая может выражаться в том, что у стрептококков вырабатывается устойчивость к медикаментозным средствам.
При проведении местной терапии важно соблюдать санитарно-гигиенические требования асептики и антисептики.
Если у одного из супругов выявляются признаки стрептококкового инфицирования, то важно обследовать более подробно все половые контакты.
Кроме того, мужчинам рекомендуется произвести исследования мазка из носоглотки на присутствие стрептококков.
При выявлении инфекции следует незамедлительно начинать профилактическое лечение.
В любом случае, важно с самого начала возникновения признаков заболевания проконсультироваться у врача, который сможет назначить комплексное обследование и выбрать наиболее оптимальный курс лечения инфекции.
Только своевременное выявление возбудителя заболевания и его чувствительности к определенным антибиотикам поможет назначить эффективные методы терапии.
Последовательное комплексное лечение инфекции даст хороший терапевтический результат.
Вы здесь:
22721 0